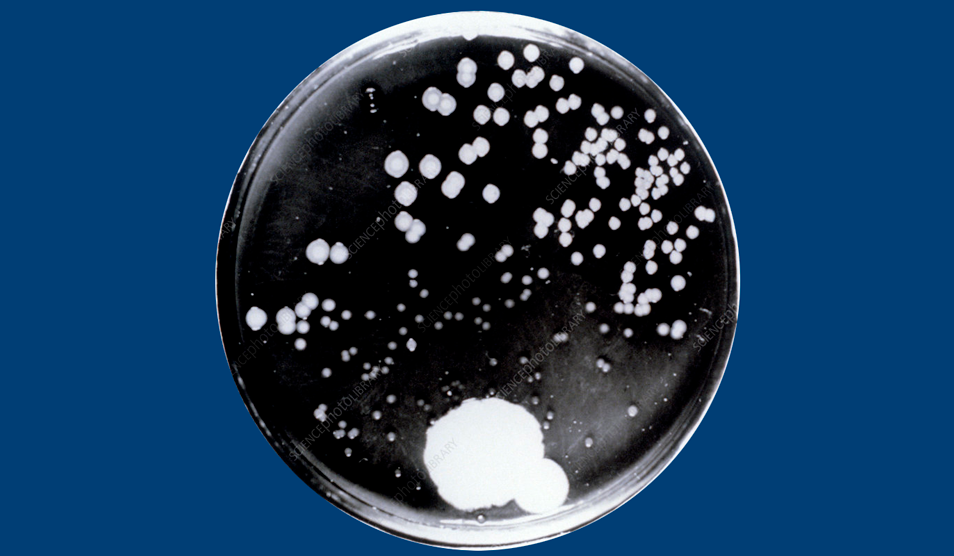

The Centre is part of the wider Fleming Initiative, established jointly by Imperial College Healthcare and Imperial College London to find equitable solutions to antimicrobial resistance at a global scale. It will be a space bringing together researchers, policymakers, clinicians, behavioural experts, commercial partners and the public to combine their shared networks, expertise and skills to tackle antimicrobial resistance. We are asking the community to share your thoughts on the initial designs and how they fit into the local context. *Please note: the images used in this consultation are artistic impressions and indicative of how the future building may look.* |
![]() |
Join us at our consultation events
Learn more and share your feedback before the consultation closes on 3 November 2025.
Public exhibition – The Bays, St Mary’s Hospital
- Thursday 16 October, 12–7pm
- Friday 17 October, 12–7pm
- Saturday 18 October, 10am–2pm
Online webinar
Wednesday 15 October 2025, 6–7pm via Zoom (Register at Webinar Registration - Zoom)
Developing our plans and design
Find out how we’ve responded to consultation feedback and see the materials shaping the new Centre.
Focusing on delivery and materials
Discover how the Fleming Centre will deliver spaces for collaboration, research and the community.
Respecting the past
Learn how the design celebrates the Bays’ heritage while creating a sustainable landmark for the future.
Indoor and outdoor spaces
See how the Centre provides welcoming spaces inside and out — for research, collaboration and the community.
Townscape views and construction
Explore how the Centre will sit within its surroundings and how construction will be managed responsibly.
Next steps and plans
See what happens next in the planning process — and how you can continue to share your feedback.
Find out what happens next
About antimicrobial resistance
AMR is one of the biggest threats to health. Learn what it means and how the Fleming Centre will help tackle it.

The Fleming Centre journey
Follow the story of how the Fleming Centre is coming to life — from royal support and major investment to local engagement and design milestones.